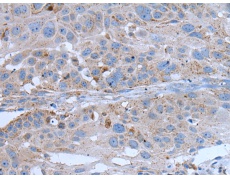
一抗

中文名稱:兔抗YPEL4多克隆抗體
|
Background: |
YPEL4 (yippee-like 4) belongs to a family of five yippee-like proteins, all of which localize to the centrosome or mitotic spindle and are widely expressed in both adult and fetal tissue. This localization plus the fact that the family of human YPEL proteins share a high degree of sequence homology across species suggests that these proteins may have a conserved function involved in cell division. YPEL4 is ubiquitously expressed in adult tissues and has been shown to associate with the major vault protein (MVP). It has been suggested that MVP can inhibit YPEL4's ability to activate Elk-1 in the MAPK signaling pathway. |
|
Applications: |
ELISA, IHC |
|
Name of antibody: |
YPEL4 |
|
Immunogen: |
Synthetic peptide of human YPEL4 |
|
Full name: |
yippee like 4 |
|
SwissProt: |
Q96NS1 |
|
ELISA Recommended dilution: |
5000-10000 |
|
IHC positive control: |
Human esophagus cancer and human lung cancer |
|
IHC Recommend dilution: |
25-100 |


 購物車
購物車 幫助
幫助
 021-54845833/15800441009
021-54845833/15800441009